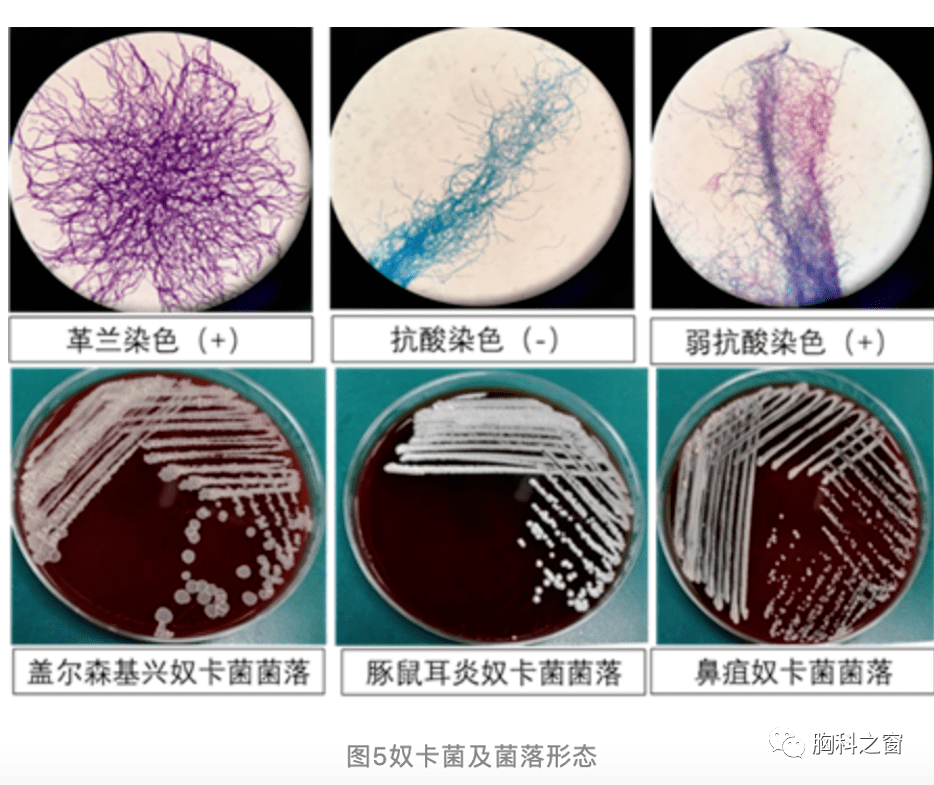
多造成肺型,播散型诺卡菌病,且多见于免疫缺陷,酒精中毒和某些肺部

酒精中毒检查单图片

辽宁庆功宴郭士强兑现承诺一醉方休 急性酒精中毒好在并无大碍
图片尺寸334x398
李先生连忙叫来救护车,将妻子送医治疗,经诊断为急性酒精中毒,应激性
图片尺寸703x267
男子聚会饮酒过量酒精中毒 送医人拒绝洗胃被诉
图片尺寸600x800
经鉴定,董某血液中酒精含量达到1.
图片尺寸425x317
酒精性肝硬化失代偿,腹水,脾亢,肺部感染,呼吸性碱中毒代谢性酸中毒
图片尺寸540x960
茉莉的尸检报告称其乙醇中毒死亡
图片尺寸255x365
来疆打工男子酒精中毒死亡 工友急寻其家人
图片尺寸550x412
囤货清单里怎么能少了它
图片尺寸580x757
酒精中毒后都有什么反应
图片尺寸1500x1000
男子酒精中毒家中丧命
图片尺寸300x400
男子聚会饮酒过量酒精中毒送医人拒洗胃被诉
图片尺寸550x733
我家用的消毒液有疾控中心新冠病毒灭菌检测报告比酒精更温和明10点开
图片尺寸736x375
男子聚会饮酒过量酒精中毒送医人拒洗胃被诉
图片尺寸428x467
怎样识别和处置急性酒精中毒
图片尺寸1620x1080
在美禁售失身酒中国热销喝超过两罐酒精中毒
图片尺寸948x531
女子裸死尸检认定强奸是诱因主因系酒精中毒
图片尺寸300x441五峰县公安局连续接到报案,共有4人疑似酒精中毒死亡
图片尺寸500x582
多造成肺型,播散型诺卡菌病,且多见于免疫缺陷,酒精中毒和某些肺部
图片尺寸934x785
图源:pixabay肌电图神经传导检测是诊断酒精中毒性周围神经病最好的
图片尺寸960x643
福建南平一酒精中毒患者在医院刺伤2人被现场控制
图片尺寸565x800
猜你喜欢:酒精中毒真实的图片酒精中毒单子照片酒精中毒化验单图片酒精中毒报告单图片酒精中毒检查报告图片酒精中毒图片酒精中毒图片真人酒精中毒诊断书图片酒精中毒证明图片酒精中毒后皮肤图片急性酒精中毒图片酒精中毒医院证明图片酒精中毒诊断证明图片酒精中毒诊断酒精中毒症状酒精中毒酒精中毒的样子酒精中毒喝醉酒精中毒诊断书酒精中毒皮肤酒精中毒漫画抑郁症检查报告单图片检查色盲专用图片大全色盲检查图检查图标色觉检查图色盲检查图背诵口诀安全检查检查ct检查高速公路排水沟施工图哈雷豪雅匪帮格拉苏蒂价格脚崴了脚面外侧鼓包毒埃迷路篮球网兜river Bishop Briggs法师老桩图片欣赏德国黑蚂蚁生精片20元帅气美女农家小院围墙图片古式抱鼓石方形